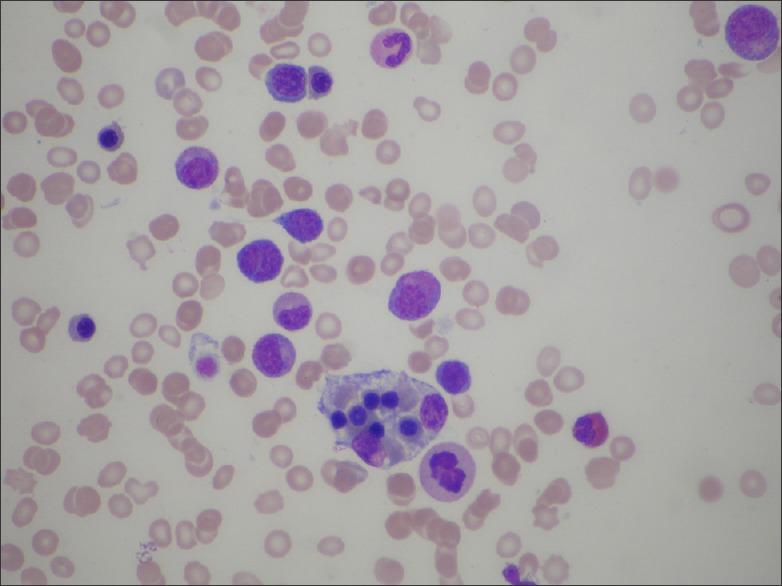

一种罕见形式皮肤淋巴瘤的显著表现。
A dramatic presentation of an unusual form of cutaneous lymphoma.
作者信息
Yang Sam Shiyao, Su Pei Qi, Tan Kong-Bing, Aw Derrick Chen-Wee
机构信息
Department of Medicine, National University Hospital, Singapore.
Department of Pathology, National University Hospital, Singapore.
出版信息
Indian J Dermatol. 2015 Jul-Aug;60(4):422. doi: 10.4103/0019-5154.160532.
We report an unusual and dramatic presentation of a rare form of cutaneous lymphoma, known as subcutaneous panniculitis-like T-cell lymphoma (SPTCL). This patient presented with a pruritic, florid and purpuric rash that was diagnosed as lobular panniculitis and treated with oral steroids for 1 year with no success. His skin lesions would return each time oral corticosteroids were being weaned off. Upon presentation to our clinic, repeated deep skin biopsies with immunohistochemical analysis coupled with the clinical history of persistent B symptoms and the presence of pancytopenia helped clinched the rare diagnosis of SPTCL with hemophagocytosis. The patient was then started on cyclosporine and dexamethasone before definitive chemotherapy. This rare and diagnostically challenging condition is commonly misdiagnosed as benign panniculitis or eczema, and highlights the importance of repeated skin biopsies.
我们报告了一种罕见的皮肤淋巴瘤——皮下脂膜炎样T细胞淋巴瘤(SPTCL)的不寻常且显著的表现。该患者出现瘙痒、皮疹明显且呈紫癜样,最初被诊断为小叶性脂膜炎,并接受了1年的口服类固醇治疗但无效。每次停用口服皮质类固醇时,他的皮肤病变都会复发。在到我们诊所就诊时,反复进行的深层皮肤活检及免疫组化分析,结合持续存在的B症状临床病史和全血细胞减少症,有助于确诊为伴有噬血细胞现象的罕见SPTCL。然后在进行确定性化疗之前,患者开始使用环孢素和地塞米松治疗。这种罕见且诊断具有挑战性的疾病通常被误诊为良性脂膜炎或湿疹,凸显了反复进行皮肤活检的重要性。